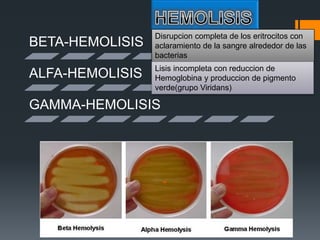
BETA-HEMOLISIS
ALFA-HEMOLISIS
GAMMA-HEMOLISIS
Disrupcion completa de los eritrocitos con
aclaramiento de la sangre alrededor de las
bacterias
Lisis incompleta con reduccion de
Hemoglobina y produccion de pigmento
verde(grupo Viridans)

1) Los estreptococos son cocos Gram positivos que se disponen en cadenas o pares y son anaerobios facultativos. 2) Existen varios grupos de estreptococos clasificados por antígenos de superficie como los grupos A, B, C y D. 3) El estreptococo beta hemolítico del grupo A causa infecciones como faringitis estreptocócica, escarlatina, impétigo y fascitis necrotizante.